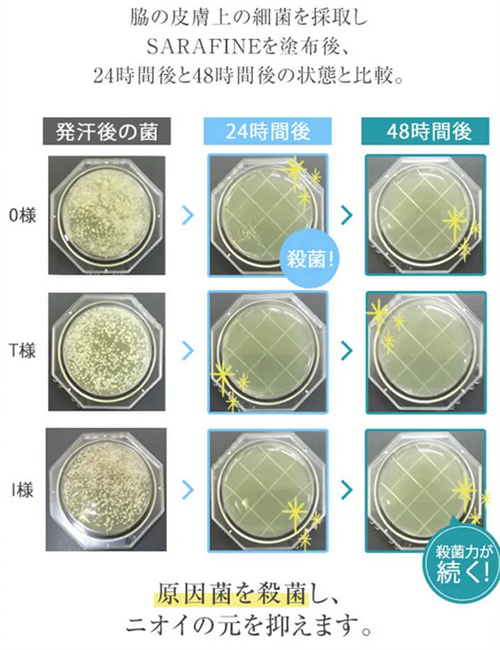

「サラフィネの効果って本当にあるの?」そんな疑問を持つあなたへ、この記事ではサラフィネの魅力を徹底解説!
サラフィネの口コミから得られるリアルな情報をもとに、効果や使い心地の秘密に迫ります。
多くの人が実感したサラフィネの効果、一体何が違うのでしょうか?
実際に使用した方々からの生の声を集めました。その結果、驚くべき事実が明らかになりました!
これを読めば、あなたもサラフィネの魅力にハマること間違いなし。
今すぐサラフィネの秘密を解き明かしましょう!
\ 初回限定 980円 /
目次
- 1 サラフィネの口コミや評判は?脇汗とニオイは改善するの?
- 2 サラフィネの口コミは嘘?効果なしの悪い口コミ
- 3 サラフィネは効果ありの良い口コミ
- 4 サラフィネの口コミまとめ
- 5 サラフィネのインスタグラムでの口コミ
- 6 サラフィネのAmazonでの口コミ
- 7 サラフィネの効果について実際に使った私の口コミをご紹介
- 8 サラフィネが口コミで高評価!人気の3つの理由
- 9 サラフィネの使い方・塗り方や使う頻度など大事なポイント
- 10 サラフィネのデメリット・メリット!長く使うならこんなところもチェック!
- 11 サラフィネをおすすめしない人はこんなタイプの方です!
- 12 サラフィネをおすすめする人はこんなタイプの方です!
- 13 サラフィネの成分と副作用のリスクについて知っておくべきこと
- 14 サラフィネのQ&A・困ったときはまずここをチェック!
サラフィネの口コミや評判は?脇汗とニオイは改善するの?

ネットで大変話題になっているサラフィネ。
良さそうだけど念のために口コミをチェックしておきたい方は多いと思いますので、効果がイメージしやすい口コミをまとめましたので参考にしてください。
| カテゴリ | 口コミの内容 |
|---|---|
| 効果なし・悪い口コミ | |
| 顔汗 | 効果が感じられなかった |
| 持続力 | 制汗作用はあるが、持続力に疑問 |
| 脇汗 | ニオイは改善、脇汗は変わらず |
| 効果あり・良い口コミ | |
| 服のニオイ | つかなくなった |
| 汗とニオイ | しっかりブロック |
| 精神的負担 | 軽減 |
| デリケートゾーン | 消臭可能 |
| デザイン | 容器がオシャレ |
サラフィネの口コミは嘘?効果なしの悪い口コミ
まずは、効果に満足されていない口コミを見ていきましょう。
顔汗はあまり効果なかったのでやっぱりワキ専用?
ワキだけでなく顔汗にも使えるらしいので買ってみた。
屋外で作業することもあり汗が止まらなかったけどワキにはかなり効き目はったと思う。
顔汗は額から相変わらず汗をかきっぱなし。
色々な使い方できると思ったのでちょっと残念。
制汗作用はあると思うけど持続力はどうかな…
手汗やワキ汗が気になるので購入しました。
制汗作用はつけたときはかなり実感できますが、動いているうちにやっぱりクリームはとれてしまうようで持続力はどうかなーって感じでした。
こういう商品は継続が重要なので、しばらく続けて様子を見ます。
商品の配送などとても丁寧で好感が持てるのでできれば続けたいです。
なにもしないよりいいかなぐらいの効果
安く買えたのでニオイ対策に購入した。
正直クリームタイプはあまり好きではないけど最近使っている人が増えているのでちょっと興味が湧いた。
このクリームでニオイは以前より少しよくなったと思う。
脇汗はあまり変わってない。
使うほど良くなるのかどうか?ちょっと疑問。
※個人の感想であり効能効果を表すものではございません。
サラフィネは効果ありの良い口コミ
効果に満足されている口コミを紹介します。
服のあの嫌なニオイがつかなくなりました!
かなりきついニオイが悩み。
スプレー制汗剤はまったく使いものにならないぐらい。
この商品を塗って1日仕事したけど服のにおいをかいだら全くわからなかった。
完全に無臭ってわけではないけど違いははっきりわかる。
とてもよい商品で肌にも優しいのでこれからも愛用できそう!
今まで使ったなかで一番最強のクリームです!
入浴後に体を拭いたタオルからワキガ臭がするほど。
クリームタイプの方がいいと人から言われ何種類か使ったけどサラフィネが自分史上最高に良かったです。
汗とニオイどちらもしっかりブロックしてくれて塗りなおししなくてもずっと消臭力が続きます。
肌の負担も軽減するのでとても快適。
ほかのものとはかなり違いますね。
オシャレな容器でお出かけ時も愛用中
ボディクリームやハンドクリームみたいで化粧ポーチにも入るサイズ。
つけた直後は少しベタっとするけどすぐにサラサラ。
朝塗って昼すぎにワキを触ったけどサラサラだった。
ワキのニオイは自分だけなら我慢できると私は接客業なので人の迷惑にならないようデオドラントは効き目のあるものしか使えない。
この商品はワキ以外にも使えていいです。
ダメ元で買ったけど期待以上で驚き!
ずっとワキガで悩み続け色々な制汗剤を使用しましたがどれも効果は感じられませんでした。
値段が高ければいいのか、ということでもなくこの商品もちょっと心配だったけど、効果の高さに驚きました。
夕方になってもワキ汗がなくニオイもかなり減りました。
かゆみもなく除毛した直後にも使えますし、精神的にも楽になったことはとても感謝です。
ヘビーユーザーです!色々使えるので試してみて!
ニオイと汗ならこれが一番いいですよ。
旦那の加齢臭もしっかり効き目を発揮してくれすし、デリケートゾーンの消臭もできる!今3回目のリピ、このクリームを塗らないと落ち着けない!ワキガで悩んでいる人や手術を考える人は一度試す価値はあると思う!
※個人の感想であり効能効果を表すものではございません。
サラフィネの口コミまとめ
良い口コミでは消臭と制汗作用について高く評価されている人はとても多かったです。
またクリームの使用はワキや顔など汗が気になるところに使えるため1本で色々使いこなせることも評価されています。
悪い口コミでは制汗作用が少ない、ニオイがまだするといった効果に関することで指摘されている人はいますが、体臭ケアは普段の生活習慣も影響するので、制汗剤以外からもアプローチは必要かと思われます。
またクリームを使いはじめの人やクリームを塗る前に肌をきれいにしない人なども効果は実感しにくいと思います。できれば使い続けて様子を見るといい商品ですね。
\ 初回限定 980円 /
サラフィネのインスタグラムでの口コミ
インスタグラムでの口コミを見ていきましょう。
この投稿をInstagramで見る
![]()
顔汗は女性にとってメイク崩れの原因になりますよね。
しかし市販の制汗剤には顔汗まで対処できるものは少ないため、サラフィネは大変活躍すしやすいクリームになると思います。
薄着になる季節こそ使い勝手の良さを感じられますよ。
この投稿をInstagramで見る
![]()
容器のデザインはシンプルなのでワキガクリームには見えないことは口コミでも評価されています。
有効成分で汗とニオイをダブルでブロックできますので夏はとくに手放せないでしょうね。
全身対応、男女兼用できることも人気がある理由なので、皆さんでクリームの魅力を実感してみてください。
この投稿をInstagramで見る
![]()
おでこや鼻は汗をかきやすくしかもメイクにも影響しやすい部分です。
顔につけられるワキガクリームなので成分にもこだわりがありユーザーの皆さんからはスキンケア的な使用感も支持されています。
洗顔後など肌がきれいなときに塗っておくとさらに汗対策はしやすくなりますよ。
この投稿をInstagramで見る
![]()
汗をかく部位ならワキ以外にも使えるのでサラフィネは機能性の高いクリームといえます。
殺菌成分が配合されているので雑菌が繁殖しやすい足にもぴったり。
冬のブーツで靴を脱ぎにくいシーンでも快適に過ごせるはずです。
この投稿をInstagramで見る
![]()
サラフィネは肌に負担がかかる添加物を配合していませんので、全身や顔に安心して使用できます。
香りがないため香水やコロンとの相性もよく制汗剤のよくある香りで人にバレることもなく内緒でニオイケアしたい人にもおすすめです。
サラフィネのAmazonでの口コミ

Amazonの口コミ評判をご紹介します!
| カテゴリ | 口コミの内容 |
|---|---|
| 洗い流し | 洗い残しが気になる場合、ハンドソープで落とせる |
| 手汗対策 | ハンドクリームみたいに伸ばすことも可能 |
| 使いやすさ | クリームなので使いやすい |
| 顔汗対策 | マスクをしても顔汗が気にならない |
| 値段 | 少し高いが、コスパはいい |
| 持ち運び | 小さくてコンパクト |
| 汗染み対策 | ワキがサラサラになり、汗染みを気にせずに過ごせる |
| 化粧崩れ対策 | 汗をしっかり押えるので、化粧崩れが少ない |
| 消臭 | ニオイも気にならない |
| 量 | 少量で効果がある、長持ち |
| 手を汚さずに塗れるか | 手を汚すが、効果は実感できる |
手で塗るため、最後洗い流す必要があるが
なかなか落ちないので星一つ減点引用:Amazon
![]()
サラフィネはしっかり肌に密着して汗腺にふたをする作用がありますので、指に残る感触が気になる方もいると思います。
洗い残しが気になる場合はハンドソープで落としてくださいね。
手汗対策にも使えるので指に残ったものはハンドクリームみたいに伸ばしてしまうことも方法です。
クリームなので使いやすいです。
マスクをすると汗かいてしまう顔にも使えるのがいいです。
少しお高いのが残念でした。引用:Amazon
![]()
値段が高いという意見は口コミでもたまにあるようですが、サラフィネは1本で全身に使えることや有効成分入りであるため安い制汗剤を何度も買いなおすよりも逆にコスパはいいと思います。
マスク生活の顔汗対策にもぴったりなので使用部位をアレンジして活用してみてください。
小さくてコンパクトなので、持ち運ぶのにもいいと思います!脇もサラサラになるので、Tシャツの汗染みを気にせずいれて良いです。今はマスク着用をすることが多くて、鼻の下などにも汗をかくのでそこにも使用してみましたが、数時間サラサラが続きました!
引用:Amazon
![]()
サラサラの持続力はサラフィネの魅力ポイントです。
とくに汗ジミが気になるワキは洋服の色も意識しておかないいけないためストレスになりますよね。
汗が気になりはじめたら塗りなおしできるので、一日快適に過ごせると思います。
汗かきで化粧崩れがすごく気になり、探していた時この商品を見つけ早速購入使用しましたが、臭いも気にならずクリーム上でのびもよく汗もしっかり押えてくれて、感謝しかありません。これからも使い続けたいです。
引用:Amazon
![]()
ウォータープルーフのコスメは色々ありますが制汗作用があるものは少ないですよね。
サラフィネは顔汗にも使えさらっと仕上がるので夏のメイク下地用品としても愛用できると思います。
たくさん塗らなくても十分でしたので、小さいですがそれなりに長持ちすると思います。持ち歩きには便利なサイズです。年中脇汗をかくタイプですが、塗り始めてから汗がほとんど出なくなったのと、ニオイもほとんどしなくなりました。手を汚さず塗れたらもっと良いですが、効果を実感できたので満足です。
引用:Amazon
![]()
クリームを塗る際に手のひらにべったりのせてしまうと取るのが大変なので、小さい部位なら指先にちょっとのせて広げることもできます。
伸びが良くべたつきがないので少量でOK。
制汗作用と消臭力はすぐに感じられると思います。
サラフィネの効果について実際に使った私の口コミをご紹介

ワキのニオイ対策として実際に私も使ってみました。
ワキガと診断はされていませんが、肉食で油っぽい食べ物が好きなので体臭は強い系だと自覚してます。
そんな私のニオイに対処できるか、サラフィネで感じたことをまとめました。
| 項目 | 詳細・感想 |
|---|---|
| テクスチャー | 適度な硬さで密着性が高い |
| 使い勝手 | ワキ以外にも首やデリケートゾーンにも使える |
| 汗対策 | 通常の制汗剤以上に効果を感じた |
| 消臭 | 瞬時にニオイがなくなる |
| 持続力 | 利用を重ねるごとに効果が高まる |
| 肌への影響 | 肌荒れなし、無添加処方 |
| 汎用性 | 顔にも使える |
| 容器・デザイン | 小さくてスタイリッシュ |
| 総評 | 生活が楽になり、積極的な対人交流が可能に |
| 口コミでの評判 | 評判が良く、決め手となった |
クリームのテクスチャーがちょうどいいです!
クリーム系のデオドラントは他社商品を以前使ったことがありますが、乳液みたいな軽いやつだとすぐにとれそうで心配。
サラフィネは適度な硬さがありワキのくぼみにもしっかり密着できるので塗りやすいです。
伸びもよく顔に使う場合もフェイス用のスキンケアみたいに使えますので、しっかり汗腺をブロックしてくれそうな印象を受けました。
汗をかく部位ならワキ以外にも使えるというのが売り文句なので、首やデリケートゾーン、ヒップなどもこれ1本で対処できることも助かりますね。
汗とニオイの効果について
サラフィネはワキガに有効な成分を配合しているので、普通の制汗剤以上に効果は実感できました。
肌にぴったりつくタイプのテクスチャーだけど軽くパッティングするとサラサラになります。
汗は完全に止まることは人間の体としてありえないと思いますが、私の場合は汗ジミ原因になる量ではなくなりました。
消臭は制汗作用以上に感じやすくとくに外出先で塗りなおすとき、クリームをつけた瞬間にニオイがなくなります。
ニオイのレベルにもよると思いますが、汗をかく前にきちんと塗り込んでおけば人前でストレスを感じることはなくなりそうです。
持続力は使うほど実感できると思います
朝塗るだけで長時間無臭になると宣伝されていますが、私の場合最初は何度か塗りなおしが必要でした。
ワキ汗がかなり多い方なので、持続力に関しては個人差がありそうです。
ただし毎日2回きちんと使っていると次第と制汗力も消臭力も高まる感じはありますので、一時的に使用するアイテムという感覚ではだめかもしれません。
容器は小さくてワキガクリームとは思えないステキなデザインです。
気になったら少し塗る、という作業を最初は繰り返したほうが根本からニオイの原因にアプローチできそうです。
\ 初回限定 980円 /
サラフィネは口コミで評判が良かったので購入しました
サラフィネという商品があることはネットの口コミを見るまで知りませんでした。
クリームタイプのデオドラントが最近人気がありますが、以前使用した商品でひどく肌荒れしたこもあり今回は念入りに口コミをチェックして決めました。
とても評判が良く肌に優しいという意見もあり、しかも制汗とニオイにしっかり効き目を感じられるとのこと。
ワキ以外にも使えることや持続力があるという評価点も気になりすぐにオーダー。
値段が安く購入できたことも理由です!
サラフィネを使ってみた私の感想まとめ
サラフィネを使って感じたことは、今まであまり意識しなかったけど人と接近する不安が軽減したことです。
積極的に会話したり近づいたりできるようになったのはサラフィネを使いはじめてからなので、ワキのトラブルを解消して普段の生活もかなり楽に。
サラフィネの殺菌と制汗効果は普通の制汗剤以上に期待していいと思います。
塗りやすく肌に負担がない無添加処方ですし長く使いたくなる優秀商品という印象を受けました。
\ 初回限定 980円 /
サラフィネが口コミで高評価!人気の3つの理由
口コミ人気が高い3つの理由をご紹介しますので、自分に向いている商品かどうかぜひ判断してみてくださいね。
| 項目 | 詳細・特長 |
|---|---|
| 有効成分とWアプローチ | 「クロルヒドロキシアルミニウム」と「イソプロピルメチルフェノール」を配合、汗とニオイに同時にアプローチ。メイク崩れやテカリ予防にも効果あり。 |
| 高密着処方で48時間持続 | 衣類の摩擦による制汗剤の流れにくい処方。最大48時間効果が持続し、塗りなおしも手軽。 |
| 肌に優しいフリー処方 | 低刺激で全身に使用可能。添加物フリーにより、かゆみや赤みがなく、黄ばみも抑制。 |
汗とニオイにWでアプローチできるクリーム制汗剤

サラフィネは制汗作用のある「クロルヒドロキシアルミニウム」 と、肌の雑菌を抑える「イソプロピルメチルフェノール」 2種の有効成分を配合しった医薬部外品のワキガクリームです。
原因となるアポクリン汗腺の汗や菌など原因を99.99%抑え、しかもワキ以外に顔汗対策としても使えるので、メイク崩れやテカリ予防としても活躍します。
肌にぴたっと密着して48時間持続!
汗を餌にする菌が繁殖するときにワキガ臭が発生。
消臭するには汗からアプローチすることがポイントになりますが、ワキは衣類の摩擦などで制汗剤も流れやすいことが特徴。
サラフィネが人気の理由は肌にしっかりのこる高密着処方を取り入れていること。
塗りなおしする際に水滴などを拭き取るだけでしっかり肌に塗布できる手軽さも人気。
顔にも使える優しい低刺激クリームなのに殺菌力は強くしかも最大48時間効果が持続します。
フリー処方で肌のかゆみや不快な症状もなし!

制汗剤でワキがかゆくなったり赤くなったりした経験はみなさんあると思います。
原因は制汗剤に刺激の強い添加物などを使用しているため。
サラフィネは全身対応でフェイスケアにもなるよう添加物をフリーにしています。
サラサラの使用感があり肌に白く残ることや洋服についてしまうこともなし。
黄ばみ原因を抑えるので大切なファッションも安心してケアできます。
\ 初回限定 980円 /
サラフィネの使い方・塗り方や使う頻度など大事なポイント
サラフィネの使い方はとても簡単でさっとひと塗りするだけですが、効果をより実感するためにも抑えておきたいポイントがあります。
| 項目 | 詳細・コツ |
|---|---|
| 塗る前の準備 | 部位を清潔に拭き取る。汗や皮脂が残っていると効果が減少する可能性あり。 |
| 塗り方 | ワキはくぼみも含め広範囲に広げる。制汗作用を高める。 |
| 使うタイミング | 朝、昼、夜、いつでも。特にニオイが発生しやすいタイミングを意識。 |
| 特に効果的な時期 | 寝る前に塗ると、寝ている間に菌の繁殖を抑えられる。 |
| 顔や首への使用 | メイク崩れ予防としても使用可。下地としても、メイクの上からも塗れる。 |
| 効果が感じられない場合 | 塗りなおしで対処。 |
使い方基本について

サラフィネを塗る前に必ず部位を綺麗に拭き取っておきましょう。
汗や皮脂があるとすでに雑菌が繁殖している可能性があるので、できるだけ清潔な状態で塗布してください。
ワキはくぼみ部分を含め少し広範囲に広げると制汗作用もさらに効果的に実感できるでしょう。
意識しておきたいポイントについて
サラフィネは朝、昼、夜、いつでも気になるときに使えますが、ニオイが発生しやすいタイミングを意識するとさらに制汗と殺菌効果が実感しやすくなりますよ。
ポイントは寝る前。
入浴後にしっかりクリームを塗りこんでおくと寝ている間に繁殖する菌を抑えることができますので朝のケアも楽に。
顔や首にも使用可能で、メイク崩れ予防として使う前は下地にしたり、外出先でメイクの上からさっと塗ることもできます。
効果が感じられないときは塗りなおしで対処してみてくださいね。
サラフィネのデメリット・メリット!長く使うならこんなところもチェック!

サラフィネの効果を期待して使ったけどあまりよくなった、という人もまれにいるようですが、デメリットとメリットを事前に理解しておくともっと納得して愛用できると思います。
デメリット
- 塗りなおししないと効果が続かない場合もある
- 値段が高い
- ドラッグストアなどお店で買えない
- 汗がゼロになることはない
- テクスチャーは好みがある
メリット
- 1本で全身に使える
- オシャレなデザインの容器で携帯しやすい
- 男女兼用できる
- 敏感肌にも使用可能
- ワキガ手術よりもコストが安い
- 精神的なストレスがなくなる
サラフィネをおすすめしない人はこんなタイプの方です!
サラフィネは堂々5冠達成した商品で実績がありますが、すべての人が満足するとは限りませんで次の場合は慎重に考えて購入してくださいね。
- 安い制汗剤で満足できる
- アレルギー成分があるので使えない
- ドラッグストアで購入したい
- 汗やニオイのトラブルは一切ない
- 使用方法を守らない
- すぐに体臭が消えると思っている
サラフィネをおすすめする人はこんなタイプの方です!

サラフィネをおすすめする人は次のような悩みがある方です。
- 頻繁に塗りなおしはしたくない
- 肌に優しい制汗剤を使いたい
- 効果がある商品に出会ったことがない
- 着たい洋服で出かけたい
- ワキガと診断された
- 顔汗でメイクが崩れやすい
- クリームのべたつきが心配
- 携帯しやすい容器がいい
- ワキガの有効成分入り商品を探している
サラフィネの成分と副作用のリスクについて知っておくべきこと
サラフィネの配合成分や副作用のリスクについて大切なポイントをまとめましたので購入前に確認しておきましょう。
| 項目 | 詳細・注意点 |
|---|---|
| 主要成分 | クロルヒドロキシアルミニウム、イソプロピルメチルフェノール。汗と菌をブロック、消臭と顔汗対策にも効果あり。 |
| アレルギー注意 | 公式サイトで全成分表を確認することが推奨されています。 |
| 副作用のリスク | 特に副作用を招く成分は使用していない。 |
| 添加物 | 合成色素、シリコン、鉱物油、紫外線吸収剤、石油系界面活性剤、香料は不使用。 |
| 使用可能部位 | ワキ以外にも顔、足、首など全身で使用可能。 |
| 品質管理 | 国内工場で厳しい基準に沿った品質管理が行われているため、安心して毎日使用できる。 |
配合成分について

サラフィネはワキガ原因のアポクリン汗腺から分泌される汗と菌をブロックする「クロルヒドロキシアルミニウム」 「イソプロピルメチルフェノール」の2種の有効成分が主要成分となっています。
消臭するだけでなく原因の汗から軽減できるため顔汗対策にもなります。
アレルギーが気になる方は公式サイトで全成分表を必ず確認しておきましょう。
副作用のリスクは大丈夫?
サラフィネは副作用を招く成分は使用していません。

「合成色素・ シリコン・ 鉱物油・紫外線吸収剤・ 石油系界面活性剤・香料」6つの添加物フリー処方。
ワキだけでなく顔、足、首など全身汗が気になるところに使えるよう配慮されています。
国内工場で厳しい基準に沿った品質管理を徹底していますので、安心して毎日使えることも特徴です。
サラフィネのQ&A・困ったときはまずここをチェック!

サラフィネによく寄せられる疑問や質問をQ&A形式でまとめましたので参考にしてください。
デリケートゾーンにも使えますか?
汗が気になる部位ならどこでも使えます。
ただしデリケートゾーンは塗布する場所に注意が必要で、粘膜に入らないよう肌表面に塗ってくださいね。
夜塗ったら朝は塗らなくても大丈夫でしょうか?
朝の外出前は制汗と殺菌効果を発揮するベストなタイミングです。
夜と朝2回使用することで持続力も感じやすくなります。
メイクする場合はいつクリームを塗ればいいでしょうか?
塗って数時間するとニオイが気になりますがどうしたらいいですか?
持続力があることはサラフィネの特徴ですが、場合によっては塗り直しで対処が必要なこともあります。
最初に塗布する際に肌をきれいにして水分を取り除くことでもっと持続力が続きます。
子供も使って大丈夫ですか?
サラフィネには肌によい美容成分も配合されており無添加処方なので敏感肌、お子様、男性も使用できます。
心配な場合はパッチテストしてからお使いください。
サラフィネ まとめ
ワキガ対策は有効な成分を使用しないと効き目が実感できません。
サラフィネは制汗と殺菌ダブルで行う有効成分入りでしかも化粧崩れまで予防できる顔汗にも使える万能クリーム。
体臭のために自分の行動範囲が制限されたり他人の視線が気になる方にサラフィネはおすすめです。
脱毛後にワキ汗が増えたなんてときもこのクリームは安全性が高く違和感なく毎日のニオイ対策に使えますよ。
\ 初回限定 980円 /
サラフィネの販売元情報
| 会社名 | (株)フロムココロ |
|---|---|
| 住所 | 〒810-0022 福岡県福岡市中央区薬院1-5-6 7F (株)フロムココロ |
| 電話番号 | 0120-556-073 |
| 代表取締役 | 折戸 昇 |
| URL | https://www.fromcocoro.com/ |
